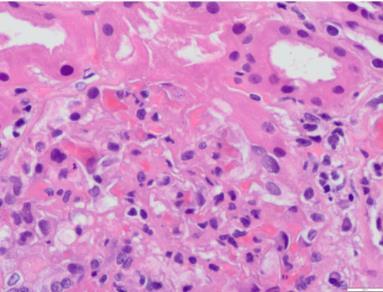

AFECTACIÓN RENAL POR LEISHMANIA EN PACIENTE CON INFECCIÓN POR EL
VIH Y EL VHB NO CONOCIDA
Resumen
La leishmaniasis visceral (LV) es una zoonosis causada por el protozoo Leishmania donovani. El inicio de los síntomas es insidioso, con malestar general, fiebre, astenia y pérdida de peso. Posteriormente, el intenso parasitismo del sistema reticuloendotelial causa pancitopenia, hepatoesplenomegalia e hipergammaglobulinemia, generando finalmente un cuadro de disfunción hepática con ictericia, hipoalbuminemia y edema. La gravedad depende de la especie de Leishmania y de la respuesta inmunológica del huésped. La mayoría de los pacientes no muestran síntomas y se curan espontáneamente; sin embargo, en inmunodeprimidos, supone con frecuencia una infección oportunista con rápida progresión potencialmente mortal. La afectación renal aparece como insuficiencia renal aguda, glomerulonefritis o nefropatía crónica. Asimismo, su tratamiento puede producir nefrotoxicidad. Presentamos el caso de un varón joven sin antecedentes, con síndrome constitucional e insuficiencia renal. Se constata coinfección por VIH y VHB, y tras varias pruebas, incluyendo biopsia renal y de medula ósea, se diagnostica de glomerulonefritis membranoproliferativa tipo 1 secundaria a LV.
Introducción
La leishmaniasis visceral (LV) o kala-azar es una zoonosis causada por el protozoo flagelado Leishmania donovani, un parásito que vive y se multiplica en los monocitos. Anualmente se producen, aproximadamente, 400.000 nuevos casos. Es endémica en las regiones tropicales y subtropicales, especialmente en Brasil y en algunos países asiáticos, con mayor incidencia en Arabia Saudita.
El reservorio son animales, como perros y ratas, y el hombre. El vector es el mosquito de arena hembra del género Phlebotomus. Las células parasitadas en el huésped pertenecen al sistema reticuloendotelial (SRE). La enfermedad también puede ser transmitida por transfusión sanguínea y por vía sexual, aunque estas son muy raras.
Después de un periodo de incubación de 2 a 6 meses, el inicio de los síntomas suele ser insidioso, con malestar general, fiebre, astenia y pérdida de peso. Posteriormente, el intenso parasitismo del SRE causa pancitopenia, hepatoesplenomegalia e hipergammaglobulinemia, lo que genera finalmente un cuadro de disfunción hepática con ictericia, caquexia, hipoalbuminemia y edema
La gravedad de la LV depende de la especie de Leishmania y de la respuesta inmunológica del huésped. La mayoría de los pacientes no muestran ningún síntoma y se curan espontáneamente. En pacientes inmunodeprimidos se manifiesta con frecuencia como una infección oportunista con progresión rápida y potencialmente mortal.
La afectación renal aparece como insuficiencia renal aguda (IRA), glomerulonefritis o nefropatía crónica. Puede causar daño a nivel intersticial, glomerular y/o vascular, que se expresa en forma de proteinuria, hematuria y leucocituria. También produce daño tubular proximal, con mayor excreción de albúmina y de proteínas, y en las excreciones urinarias de sodio, potasio, calcio, fósforo, magnesio y ácido úrico, con los consecuentes déficits plasmáticos.
Asimismo, el tratamiento de la propia LV puede ser responsable de la afectación renal y en ella los distintos fármacos efectivos tienen un alto riesgo de nefrotoxicidad.
La nefropatía crónica se caracteriza principalmente por descenso del filtrado glomerular (FG), así como dificultad en la concentración y la acidificación de la orina, y se encuentra hasta el 30% de acidosis tubular renal distal según algunas series. La sospecha diagnóstica de LV es inicialmente clínica e implica un amplio diagnóstico diferencial con enfermedades como brucelosis, esquistosomiasis, paludismo, histoplasmosis, linfomas y sepsis. La confirmación está determinada por la demostración del parásito en los tejidos afectados. La presencia de amastigotes en el sistema mononuclear fagocítico de la médula ósea supone el 90% de resultados positivos, seguida de la biopsia hepática y renal.
Sin embargo, este procedimiento puede ser complicado en pacientes con afectación grave por la enfermedad, por lo que se han desarrollado pruebas serológicas alternativas. Las pruebas de aglutinación, los ensayos inmunoenzimáticos (ELISA), la inmunofluorescencia indirecta (IFI) y las pruebas inmunocromatográficas basadas en rK39 (ICT) son las más utilizadas.
En estudios realizados desde 2010, las pruebas de aglutinación directa e ICT mostraron los mejores resultados en cuanto a sensibilidad, especificidad y valores diagnósticos, mientras que ELISA, a pesar de poseer buena especificidad (99%), tiene baja sensibilidad (37%) y es falsamente positiva en una gran proporción de individuos sanos, y permanece positiva durante largos periodos después de la curación.
Caso Clínico
Presentamos el caso de un varón de 40 años de raza negra que consulta en urgencias por síndrome constitucional y epistaxis leve.
Es originario de Ghana y reside en España desde hace 16 años. No presenta antecedentes familiares conocidos de interés, ni viajes fuera de España desde hace 10 años. Convive con compañeros de piso y sin animales.
Entre sus antecedentes personales destacan consumo previo de cocaína con episodios de epistaxis en el contexto, enolismo y hábito tabáquico hasta hace 1 año, sin tratamiento habitual
El paciente consulta en urgencias por malestar general, epistaxis leve autolimitada, astenia, náuseas, vómitos de contenido alimenticio y sensación febril no medida con termómetro de varias semanas de evolución. Sin alteraciones en el hábito intestinal, presenta deposiciones de características normales, con pérdida ponderal no cuantificada. La diuresis es mantenida con orina de coloración oscura.
En la exploración física presenta estado general regular, presión arterial de 145/90 mmHg, temperatura de 37,5 °C y deshidratación mucocutánea. Tiene lesiones herpéticas en el labio superior y en el inferior. No presenta focalidad neurológica. La auscultación es rítmica y sin soplos, con murmullo vesicular conservado. Presenta abdomen no doloroso, ruidos hidroaéreos presentes y hepatomegalia no dolorosa, sin esplenomegalia. No presenta edemas.
Se realizan los siguientes procedimientos diagnósticos al ingreso:
• Analítica: hemoglobina, 9,4 g/dl; volumen corpuscular medio, 76; reticulocitos, 2,40%. Frotis, algún esquistocito aislado; plaquetas, 81.000; leucocitos, 2.250; : neutrófilos absolutos, 1,06; tiempo de protrombina, 74%; cociente internacional normalizado, 1,6; glucosa, 85 mg/dl; creatinina, 1,90 mg/dl; filtrado glomerular, 43 ml/min; sodio, 125 mEq/l; potasio, 3,80 mEq/l; cloro, 89 mEq/l; lipasa, 384 U/l, aspartato-transaminasa, 190; alaninatransaminasa, 103; glutamil-transferasa, 487; fosfatasa ácida, 161; bilirrubina total, 1,10 mg/dl;
bilirrubina directa, 0,70 mg/dl; proteínas totales, 10,14 mg/dl; lactato-deshidrogenasa, 363 U/l; ácido láctico, 28,1; gasometría venosa: pH, 7,419; pCO2, 40,8; bicarbonato, 25,7; ferritina, 2.563 ng/ml; triglicéridos, 193 mg/dl. Orina: microhematuria y proteinuria, 0,7 g/l.
• Radiografía de tórax: índice cardiotorácico normal, hilios engrosados con adenopatías calcificadas. Silueta cardiomediastínica y parénquimas sin otros hallazgos.
• Prueba rápida de malaria: negativa.
Se procede a ingreso hospitalario para continuar estudio con las siguientes pruebas complementarias:
• Ecografía abdominal: riñones de tamaño agrandado (14 cm) y ecoestructura normal. No presenta ectasia pielocalicial. Hay esplenomegalia de 18 cm, con probables hemangiomas esplénicos y hepático
• Tomografía por emisión de positrones tomografía computarizada: moderada captación difusa en ambas glándulas parótidas sugerente de proceso inflamatorio, infeccioso, autoinmune, etc. Presenta adenopatías laterocervical derecha y mediastínicas hipermetabólicas, baja captación difusa en ambos parénquimas pulmonares y esplenomegalia con incremento metabólico difuso, todo ello sugerente de proceso reactivo/inflamatorio. Hay disminución de la captación renal bilateral compatible con insuficiencia renal. No hay otros hallazgos indicativos de lesiones neoplásicas.
• Ecocardiograma: hipertrofia concéntrica grave del ventrículo izquierdo con fracción de eyección del ventrículo izquierdo conservada.
En la tabla 1 se muestran los resultados del estudio analítico.
Ante los resultados de las pruebas complementarias con serología positiva para el VIH y el VHB, con persistencia de fracaso renal, se decide realización de biopsia renal.
A continuación, se presenta el informe de la biopsia renal.
Casos Clínicos
Microscopia óptica Descripción microscópica (figs. 1 y 2): media de 12 glomérulos con expansión mesangial e irregular incremento de la celularidad. Se observa leve hiperplasia e hipertrofia podocitaria, así como múltiples oquedades en cortes tangenciales de la membrana basal, observadas con plata metanamina. En algunos de los glomérulos se observan amastigotes de Leishmania en los citoplasmas de los podocitos y de alguna célula endotelial. No hay colapso de los ovillos capilares. Los vasos no presentan alteraciones. Hay un intersticio con infiltrado inflamatorio rico en células plasmáticas policlonales (kappa y lambda positivas; IgG4 negativas). Hay leve daño tubular con aislados cilíndricos hemáticos.
Figura 1. Glomérulos con amastigotes de Leishmania en su interior.
Figura 2. Tinción con ácido peryódico de Schiff. Glomérulos con amastigotes de Leishmania. Infiltrado inflamatorio intersticial de células plasmáticas policlonales.
Inmunofluorescencia: IgG (+), IgM (+) y C3 (2+). Negatividad de IgA, fibrinógeno, kappa, lambda, C1q y C4d.
Microscopia Electrónica (Fig. 3)
Presencia de algunos depósitos electrón-densos granulares a nivel intramembranoso, subendotelial y en el mesangio. Fusión pedicelar focal. Alteraciones compatibles con afectación renal por LV de patrón membranoproliferativo.
Figura 3. Médula ósea. Tinción de Giemsa (603). Amastigotes en el citoplasma de histiocitos en su interior.
Biología Molecular
Análisis molecular del ADN extraído de la biopsia renal. Detección del gen TOP2 de Leishmania (donovani/infantum) mediante el kit RealCycler DONO (BioRad). Control de amplificación: positivo.
Asimismo, dado el grado de afectación hematológica, se realiza también biopsia de medula ósea (v. fig. 3; fig. 4). Se evidencian abundantes histiocitos con amastigotes de Leishmania en su interior, imágenes de hemofagocitosis y áreas de degeneración mucinosa del estroma. Se observa plasmocitosis policlonal.
El análisis molecular del ADN extraído del extendido de aspirado de médula ósea detecta el gen TOP2 de Leishmania (donovanii/infantum) mediante el kit RealCycler DONO (BioRad).
Evolución
Se objetiva antígeno de superficie del virus de la hepatitis B positivo con carga viral muy elevada y serología viral positiva para el VIH, desconocidos previamente, así como anticuerpos antinucleares positivos con anticuerpos anti-ADN y ANE (antígeno nuclear extraíble) negativos; y anticuerpos anticitoplasmáticos de neutrófilos antiproteinasa 3 positivos a título bajo, lo que interpretamos como una respuesta inmunológica defectuosa propia del paciente inmunodeprimido. En la tabla 1 se aprecia una profunda depleción de linfocitos CD3, en relación con la enfermedad por el VIH no tratada.
Figura 4. Médula ósea. Tinción de hematoxilina-eosina (403). Amastigotes en el citoplasma de histiocitos. Abundantes células plasmáticas
El paciente presenta evolución tórpida, con persistencia de febrícula, escalofríos y malestar general. Se aísla en el hemocultivo Staphylococcus aureus sensible a meticilina, tratado de forma dirigida con daptomicina. La función renal empeora progresivamente, con sedimento urinario activo.
Ante esta situación, se realiza biopsia renal, que muestra un patrón de glomerulonefritis membranoproliferativa tipo 1 secundaria a leishmaniasis; la biopsia de médula ósea confirma la presencia de Leishmania con patrón de hemofagocitosis secundario.
Por tanto, nos encontramos ante un caso de un paciente gravemente inmunodeprimido por enfermedad por el VIH, con reactivación del VHB, citomegalovirus y herpesvirus tipo 1, con enfermedad por leishmaniasis visceral.
Se inicia tratamiento antirretroviral y el paciente presenta clara mejoría del estado general. Se instaura también tratamiento con anfotericina B liposomal con mejoría progresiva. La función renal inicialmente mejora hasta 1,2 mg/dl de creatinina, pero a la semana de tratamiento se objetiva nuevo empeoramiento de esta hasta 1,8 mg/dl, atribuido a la nefrotoxicidad tubular del fármaco, lo que obliga a reducir su dosis.
Al alta se continúa con tratamiento ambulatorio con anfotericina B liposomal de manera semanal, terapia antihipertensiva con 2 fármacos, incluyendo antagonistas de los receptores de la angiotensina II, y terapia antirretroviral. Finalmente se suspende el tratamiento con anfotericina B liposomal al mes del inicio por deterioro de la función renal y actualmente se mantiene tratamiento con miltefosina, con una función renal estabilizada de creatinina (1,4 mg/dl) y filtrado glomerular de 61 ml/min.
Discusión Y Conclusiones
Se trata de un caso de diagnóstico complejo de un varón joven sin ningún antecedente conocido, con síndrome constitucional como motivo de consulta inicial. Se constata coinfección por el VIH y el VHB, y finalmente la leishmaniasis visceral o la enfermedad de kala-azar es la responsable de la afectación renal y el empeoramiento de las manifestaciones clínicas.
La infección renal aguda es la manifestación más frecuente de la leishmaniasis (hasta en el 46% de los casos) y se relaciona con infecciones secundarias, factores hemodinámicos, el uso de anfotericina B y la infección parasitaria en sí por invasión directa del parénquima renal, especialmente en pacientes inmunocomprometidos.
La glomerulonefritis mesangial y membranoproliferativa son los tipos más frecuentes de enfermedades glomerulares, aunque también se han descrito casos de glomerulonefritis rápidamente progresiva y de amiloidosis secundaria. El depósito de inmunocomplejos en el tejido renal y la activación de las moléculas de adhesión de células T son los responsables de su patogenia.
La leishmaniasis es una enfermedad oportunista poco frecuente en los pacientes con VIH, lo que dificultó el diagnóstico hasta que se realizó la biopsia de médula ósea y renal.
Ante un paciente con pancitopenia, hepatoesplenomegalia y fiebre se debe tener en cuenta la patología producida por Leishmania. Si no se conocen sus antecedentes clínicos previos, hay que sospechar enfermedades que condicionen inmunosupresión.
La rápida instauración del tratamiento antirretroviral, sumado a la terapia específica para la infección oportunista, condicionó la buena evolución del paciente.
❖ Identificación de todos los microorganismos y su relación clínica asociada al caso del artículo.
El documento describe un caso clínico en el que se identifican varios microorganismos y su relación clínica, detallados a continuación:
1. Leishmania donovani (o infantum):
o Relación clínica: Es el agente causal de la leishmaniasis visceral (LV) o kala-azar, que en este caso provocó una afectación renal caracterizada por glomerulonefritis membranoproliferativa tipo 1. En pacientes inmunodeprimidos, como en este caso, la leishmaniasis actúa como una infección oportunista con riesgo de progresión rápida y mortal.
o Hallazgos clínicos: Amastigotes de Leishmania se detectaron en biopsias renales y de médula ósea. Provocaron hemofagocitosis y depósitos intramembranosos en los glomérulos.
Adaptado de: Leishmaniasis, centropara el control de enfermedades, 2024 (https://www.cdc.gov/dpdx/leishmaniasis/index.html)
2. Virus de la inmunodeficiencia humana (VIH):
o Relación clínica: Causó inmunosupresión grave, facilitando la infección por Leishmania. La enfermedad por VIH no tratada también se asoció con alteraciones inmunológicas como depleción de linfocitos CD3 y defectos en la respuesta inmunitaria.
o Hallazgos clínicos: Serología positiva y cuadro de pancitopenia.
3. Virus de la hepatitis B (VHB):
o Relación clínica: Coinfección no diagnosticada previamente. Contribuyó al deterioro del estado general del paciente y posiblemente al daño hepático, aunque su implicación directa en la afectación renal no se evidenció de manera clara.
o Hallazgos clínicos: Carga viral elevada y antígeno de superficie positivo.
Adaptado de: Lecturio, Oiseth et al, 2024 (https://www.lecturio.com/es/concepts/virus-de-la-hepatitis-b/)
4. Citomegalovirus y herpesvirus tipo 1:
o Relación clínica: Coinfecciones en el contexto de la inmunosupresión por VIH. Se identificaron lesiones herpéticas (por HSV-1) y posiblemente contribuyeron a la inflamación sistémica.
o Hallazgos clínicos: Lesiones labiales compatibles con infección por HSV-1 y diagnóstico serológico.
Adaptado de: El citomegalovirus puede acelerar la progresión tumoral, misistemainmune, 2014 (https://www.misistemainmune.es/enfermedades-sistema-inmunitario/el-citomegalovirus-puedeacelerar-la-progresion-tumoral)
5. Staphylococcus aureus (sensible a meticilina):
o Relación clínica: Se aisló en hemocultivo y se trató con daptomicina. Podría haber exacerbado la inflamación sistémica y contribuido al malestar general.
o Hallazgos clínicos: Infección secundaria documentada durante la hospitalización.
Adaptado de: S aureus, CDC Public Health Image Library (PHIL) 2021(https://www.insst.es/agentes-biologicos-basebio/bacterias/staphylococcus-aureus) Resumen
El caso ilustra la interacción de múltiples infecciones (Leishmania, VIH, VHB, HSV-1, citomegalovirus y Staphylococcus aureus) en un paciente gravemente inmunocomprometido, con manifestaciones clínicas complejas que incluyen insuficiencia renal, hepatoesplenomegalia y pancitopenia.
❖ De los microorganismos identificados, registre la triada epidemiológica de los que considere son los más relevantes en el caso clínico en estudio.
La tríada epidemiológica analiza los factores del huésped, agente y ambiente para comprender la dinámica de una enfermedad (como se representa en la imagen 5)
Adaptado de: Triada Epidemiológica, Feel, 2020,( https://youtu.be/nJC1xhSaMo?si=xjKdUs4_Xi9wZREb).
En este caso, los microorganismos más relevantes son Leishmania donovani y el Virus de la inmunodeficiencia humana (VIH). A continuación, se describen sus respectivas tríadas:
TRIADA EPIDEMIOLÓGICA
Protozoo intracelular obligado del género Leishmania.
Se multiplica en células del sistema reticuloendotelial, como macrófagos y monocitos.
Leishmania donovani
Transmisión: principalmente a través de la picadura de mosquitos hembra del género Phlebotomus (regiones del Viejo Mundo) o Lutzomyia (Nuevo Mundo).
Patogenicidad: en inmunocomprometidos, como este caso, causa
Paciente inmunosuprimido por VIH avanzado.
Factores de riesgo: Inmunosupresión grave (pancitopenia, linfopenia).
Edad: adulto joven (40 años).
Comorbilidades: coinfección por VIH y VHB.
Endemicidad: enfermedad prevalente en áreas tropicales y subtropicales, pero también en migrantes provenientes de zonas endémicas como Ghana (país de origen del paciente).
Condiciones socioeconómicas: Migrante con probable exposición inicial en Ghana y diagnóstico tardío en España.
Vector: presencia de mosquitos en las regiones endémicas,
Virus de la inmunodeficiencia humana (VIH)
infecciones oportunistas graves.
Retrovirus del género Lentivirus
Transmisión: contacto con fluidos corporales (sangre, semen, leche materna).
Patogenicidad: infección crónica que destruye linfocitos CD4+, provocando inmunosupresión progresiva.
Paciente adulto joven, sin tratamiento previo para VIH.
Factores de riesgo:
Estilo de vida previo (enolismo, tabaquismo, consumo de cocaína).
Ser un migrante que pudo adquirir la infección en un contexto con menor acceso a pruebas o tratamientos oportunos.
aunque no en el entorno actual (España).
Acceso desigual a la salud: diagnóstico de VIH desconocido hasta la presentación clínica grave.
Presencia de coinfecciones oportunistas debido a inmunosupresión (Leishmania, herpesvirus, citomegalovirus).
Migración desde áreas de alta prevalencia de VIH (Ghana) a un entorno donde las condiciones inmunológicas deterioradas no fueron abordadas a tiempo.
Estas dos infecciones, aunque distintas en su origen y transmisión, tienen una relación sinérgica, ya que el VIH potencia la progresión de la leishmaniasis, que a su vez actúa como una infección oportunista en el contexto de inmunosupresión severa.
❖ Del caso clínico mencione los estudios realizados al paciente para el diagnóstico y explique los que considere que son relevantes en este caso. Del caso clínico, se realizaron varios estudios para llegar al diagnóstico final. A continuación, se describen los principales procedimientos y se explican los más relevantes:
1. Estudios Iniciales:
• Analítica sanguínea y urinaria:
o Resultados destacados:
▪ Pancitopenia: hemoglobina baja (9.4 g/dl), leucocitos (2,250/µL) y plaquetas (81,000/µL).
▪ Insuficiencia renal: creatinina elevada (1.9 mg/dL), filtrado glomerular reducido (43 mL/min).
▪ Hiponatremia (125 mEq/L).
▪ Proteinuria (0.7 g/L) y microhematuria en orina.
▪ Hepatopatía: aumento de enzimas hepáticas (AST, ALT) y bilirrubina directa (0.7 mg/dL).
• Pruebas de imagen:
o Radiografía de tórax: adenopatías calcificadas sin signos infecciosos pulmonares.
o Ecografía abdominal: riñones agrandados con ecoestructura normal y esplenomegalia (18 cm).
o PET-TAC: captación renal disminuida, esplenomegalia con actividad metabólica elevada y adenopatías mediastínicas.
• Serología:
o VIH y VHB positivos (no conocidos previamente).
o Anticuerpos antinucleares positivos, sin alteraciones en ADN ni ANE, indicando una inmunoregulación defectuosa.
2. Estudios Relevantes para el Diagnóstico Final:
a. Biopsia renal
• Importancia: Es crucial para determinar la causa de la insuficiencia renal.
• Hallazgos:
o Glomerulonefritis membranoproliferativa tipo 1.
o Amastigotes de Leishmania en citoplasmas de podocitos y células endoteliales.
o Daño tubular leve y presencia de cilindros hemáticos.
• Relevancia: Confirmó la invasión directa de Leishmania en el tejido renal y su rol en la patogénesis.
b. Biopsia de médula ósea
• Importancia: Es útil para diagnosticar enfermedades sistémicas como la leishmaniasis visceral.
• Hallazgos:
o Abundantes histiocitos con amastigotes de Leishmania.
o Hemofagocitosis, indicativa de una respuesta inmunitaria alterada.
• Relevancia: Confirmó la leishmaniasis visceral como causa subyacente del cuadro clínico.
c. Biología molecular
• Prueba realizada: PCR para detectar el gen TOP2 de Leishmania donovani/infantum.
• Relevancia: Confirmó la presencia del parásito en las muestras de biopsia renal y de médula ósea, ratificando el diagnóstico etiológico.
d. Hemocultivo
• Resultado: Aislamiento de Staphylococcus aureus sensible a meticilina.
• Relevancia: Aunque secundario, orientó el tratamiento para prevenir complicaciones infecciosas adicionales.
3. Estudios Complementarios Importantes:
• Ecocardiograma: Hipertrofia del ventrículo izquierdo; detectó complicaciones cardiovasculares relacionadas con la enfermedad sistémica.
• Prueba de malaria: Negativa; descartó otro diagnóstico diferencial en un paciente proveniente de una región endémica.
Conclusión:
Los estudios más relevantes en este caso son la biopsia renal, la biopsia de médula ósea, y la biología molecular, ya que confirmaron la presencia de Leishmania como el agente causal de la insuficiencia renal y el cuadro clínico sistémico. Estas pruebas, junto con la serología y los estudios de imagen, permitieron diagnosticar y tratar eficazmente al paciente.
❖ Del caso clínico mencione los tratamientos realizados al paciente y explique los que considere que son relevantes en el estudio.
Tratamientos realizados al paciente:
1. Tratamiento específico para la leishmaniasis visceral (LV):
o Anfotericina B liposomal:
▪ Dosis inicial: Se administró como tratamiento de primera línea.
▪ Efectos secundarios: Produjo nefrotoxicidad tubular, lo que obligó a reducir la dosis.
▪ Evolución: A pesar de la reducción, inicialmente mejoró la función renal (creatinina: 1.2 mg/dl), pero luego deterioró nuevamente (1.8 mg/dl).
▪ Relevancia: Fundamental para eliminar el parásito y mejorar el cuadro clínico sistémico. Sin embargo, su nefrotoxicidad complicó el manejo renal del paciente.
o Miltefosina:
▪ Inicio: Sustituyó la anfotericina B debido al deterioro renal.
▪ Evolución: Logró estabilizar la función renal (creatinina: 1.4 mg/dl, filtrado glomerular: 61 ml/min).
▪ Relevancia: Es un fármaco oral efectivo en casos de leishmaniasis visceral, particularmente útil cuando los tratamientos parenterales no son tolerados.
2. Terapia antirretroviral (TAR):
o Objetivo: Tratar la infección por VIH, mejorar la inmunidad y prevenir nuevas infecciones oportunistas.
o Relevancia: Es crucial para estabilizar la inmunosupresión que permitió el desarrollo de la leishmaniasis como infección oportunista. La instauración temprana de TAR fue clave para la evolución positiva del paciente.
3. Tratamiento antibiótico:
o Daptomicina:
▪ Indicada para tratar la infección secundaria por Staphylococcus aureus sensible a meticilina, aislado en hemocultivo.
▪ Relevancia: Evitó complicaciones adicionales por bacteriemia en un paciente gravemente inmunocomprometido.
4. Terapia antihipertensiva:
o Fármacos utilizados: Antagonistas de los receptores de la angiotensina II.
o Relevancia: Ayudaron a controlar la hipertensión secundaria a la nefropatía y a proteger la función renal restante.
5. Manejo sintomático:
o Hidratación y corrección de desequilibrios electrolíticos (hiponatremia).
o Soporte nutricional debido al síndrome constitucional severo.
Tratamientos más relevantes en el estudio:
a. Anfotericina B liposomal y miltefosina:
• Fueron los tratamientos dirigidos contra Leishmania donovani. La anfotericina B es el estándar de oro para la leishmaniasis visceral, mientras que la miltefosina permitió continuar el manejo de la enfermedad tras la suspensión de la anfotericina por toxicidad renal.
b. Terapia antirretroviral (TAR):
• La restauración parcial de la función inmunológica a través del TAR fue esencial para controlar no solo el VIH sino también las coinfecciones oportunistas, incluida la leishmaniasis.
c. Daptomicina:
• Aunque secundaria, su administración fue importante para prevenir la sepsis por Staphylococcus aureus, una posible causa de descompensación general en un paciente con inmunosupresión severa.
Conclusión:
El tratamiento combinado para la leishmaniasis visceral (anfotericina B y miltefosina) y el inicio del TAR son los pilares clave que permitieron la mejoría clínica y la estabilización del paciente. La terapia dirigida a infecciones secundarias y al control de las complicaciones renales complementó el manejo integral del caso.
❖ Complemente el desarrollo del caso con datos epidemiológicos a nivel nacional con los microorganismos del caso que considere más relevantes.
Datos epidemiológicos en Colombia relacionados con los microorganismos más relevantes mencionados en el artículo:
1. Leishmania spp. (Leishmaniasis visceral y cutánea)
• Situación en Colombia:
o La leishmaniasis es una enfermedad endémica en el país, particularmente en zonas rurales y selváticas de regiones tropicales.
o Según el Instituto Nacional de Salud (INS), Colombia registra más de 7,000 casos anuales de leishmaniasis, siendo la leishmaniasis cutánea (LC) la más frecuente (95% de los casos).
o La leishmaniasis visceral (LV) es menos común, pero sigue siendo una preocupación de salud pública. Es considerada una enfermedad desatendida con alto subregistro, afectando principalmente a pacientes inmunosuprimidos o niños pequeños.
• Zonas de endemicidad:
o Las regiones con mayor incidencia son Amazonas, Chocó, Meta, Guaviare, Tolima y Nariño, donde predominan condiciones ambientales favorables para los vectores (mosquitos flebótomos del género Lutzomyia).
• Factores de riesgo:
o Contacto humano en áreas selváticas debido a actividades laborales (agricultura, minería, turismo).
o Migración desde zonas endémicas rurales a áreas urbanas.
• Relación con el caso clínico:
o Aunque el paciente del caso es originario de Ghana, los pacientes inmunodeprimidos en Colombia también son vulnerables a infecciones por Leishmania, especialmente los coinfectados con VIH, como se evidencia en estudios nacionales.
2. Virus de la inmunodeficiencia humana (VIH)
• Situación en Colombia:
o Según cifras de ONUSIDA y el Ministerio de Salud, en Colombia había aproximadamente 170,000 personas viviendo con VIH en 2023, con una prevalencia del 0.4% en la población general.
o El acceso al tratamiento antirretroviral ha mejorado en el país, pero aún hay brechas significativas en diagnóstico temprano y manejo de infecciones oportunistas.
• Distribución y características:
o La mayoría de los casos se concentran en zonas urbanas de departamentos como Antioquia, Valle del Cauca, Bogotá, y Atlántico.
o Las coinfecciones por VIH y enfermedades oportunistas como tuberculosis, criptococosis y leishmaniasis visceral son comunes en regiones endémicas.
• Relación con el caso clínico:
o La coinfección VIH-Leishmania en Colombia ha sido reportada en pacientes inmunocomprometidos, principalmente en regiones donde ambos patógenos son prevalentes. En estos casos, la leishmaniasis actúa como una infección oportunista con alta mortalidad si no se trata adecuadamente.
3. Hepatitis B (VHB)
• Situación en Colombia:
o El VHB afecta a aproximadamente 1% de la población colombiana, según estudios epidemiológicos.
o El país cuenta con un programa de vacunación desde 1993, lo que ha reducido significativamente la transmisión vertical y los casos nuevos en niños.
o La transmisión en adultos sigue asociada con prácticas de riesgo como uso de drogas intravenosas, relaciones sexuales sin protección y procedimientos médicos inseguros.
• Relación con el caso clínico:
o Coinfecciones VIH-VHB son frecuentes debido a vías de transmisión similares. En pacientes con VIH, el VHB puede exacerbar el daño hepático e incrementar la gravedad de las coinfecciones oportunistas.
Importancia epidemiológica del estudio en Colombia:
El caso resalta la relevancia de las infecciones oportunistas como la leishmaniasis visceral en pacientes inmunosuprimidos por VIH. Dado que ambas enfermedades están presentes en Colombia, especialmente en zonas endémicas, el caso subraya la necesidad de:
1. Diagnóstico temprano: Implementar estrategias de tamizaje en pacientes con VIH, particularmente en áreas endémicas.
2. Tratamiento adecuado: Asegurar el acceso a terapias efectivas como anfotericina B liposomal y TAR.
3. Prevención: Fortalecer los programas de control vectorial y de vacunación para enfermedades como el VHB.
Este caso ofrece un ejemplo claro de cómo las coinfecciones complejas pueden presentarse en contextos clínicos colombianos y la importancia de un enfoque multidisciplinario para su manejo.
Referencias bibliográficas de las fuentes utilizadas para el análisis del contexto epidemiológico en Colombia:
Instituto Nacional de Salud (INS). (2023). Informe anual de leishmaniasis en Colombia Recuperado de www.ins.gov.co
Ministerio de Salud y Protección Social de Colombia. (2023). Situación actual del VIH/SIDA en Colombia. Recuperado de www.minsalud.gov.co
Organización Panamericana de la Salud (OPS). (2023). Hepatitis virales en las Américas: Informe 2023. Washington, D.C.: OPS. Recuperado de www.paho.org
ONUSIDA. (2023). Datos sobre el VIH en América Latina y el Caribe Recuperado de www.unaids.org
World Health Organization (WHO). (2022). Leishmaniasis fact sheet Recuperado de https://www.who.int/news-room/fact-sheets/detail/leishmaniasis